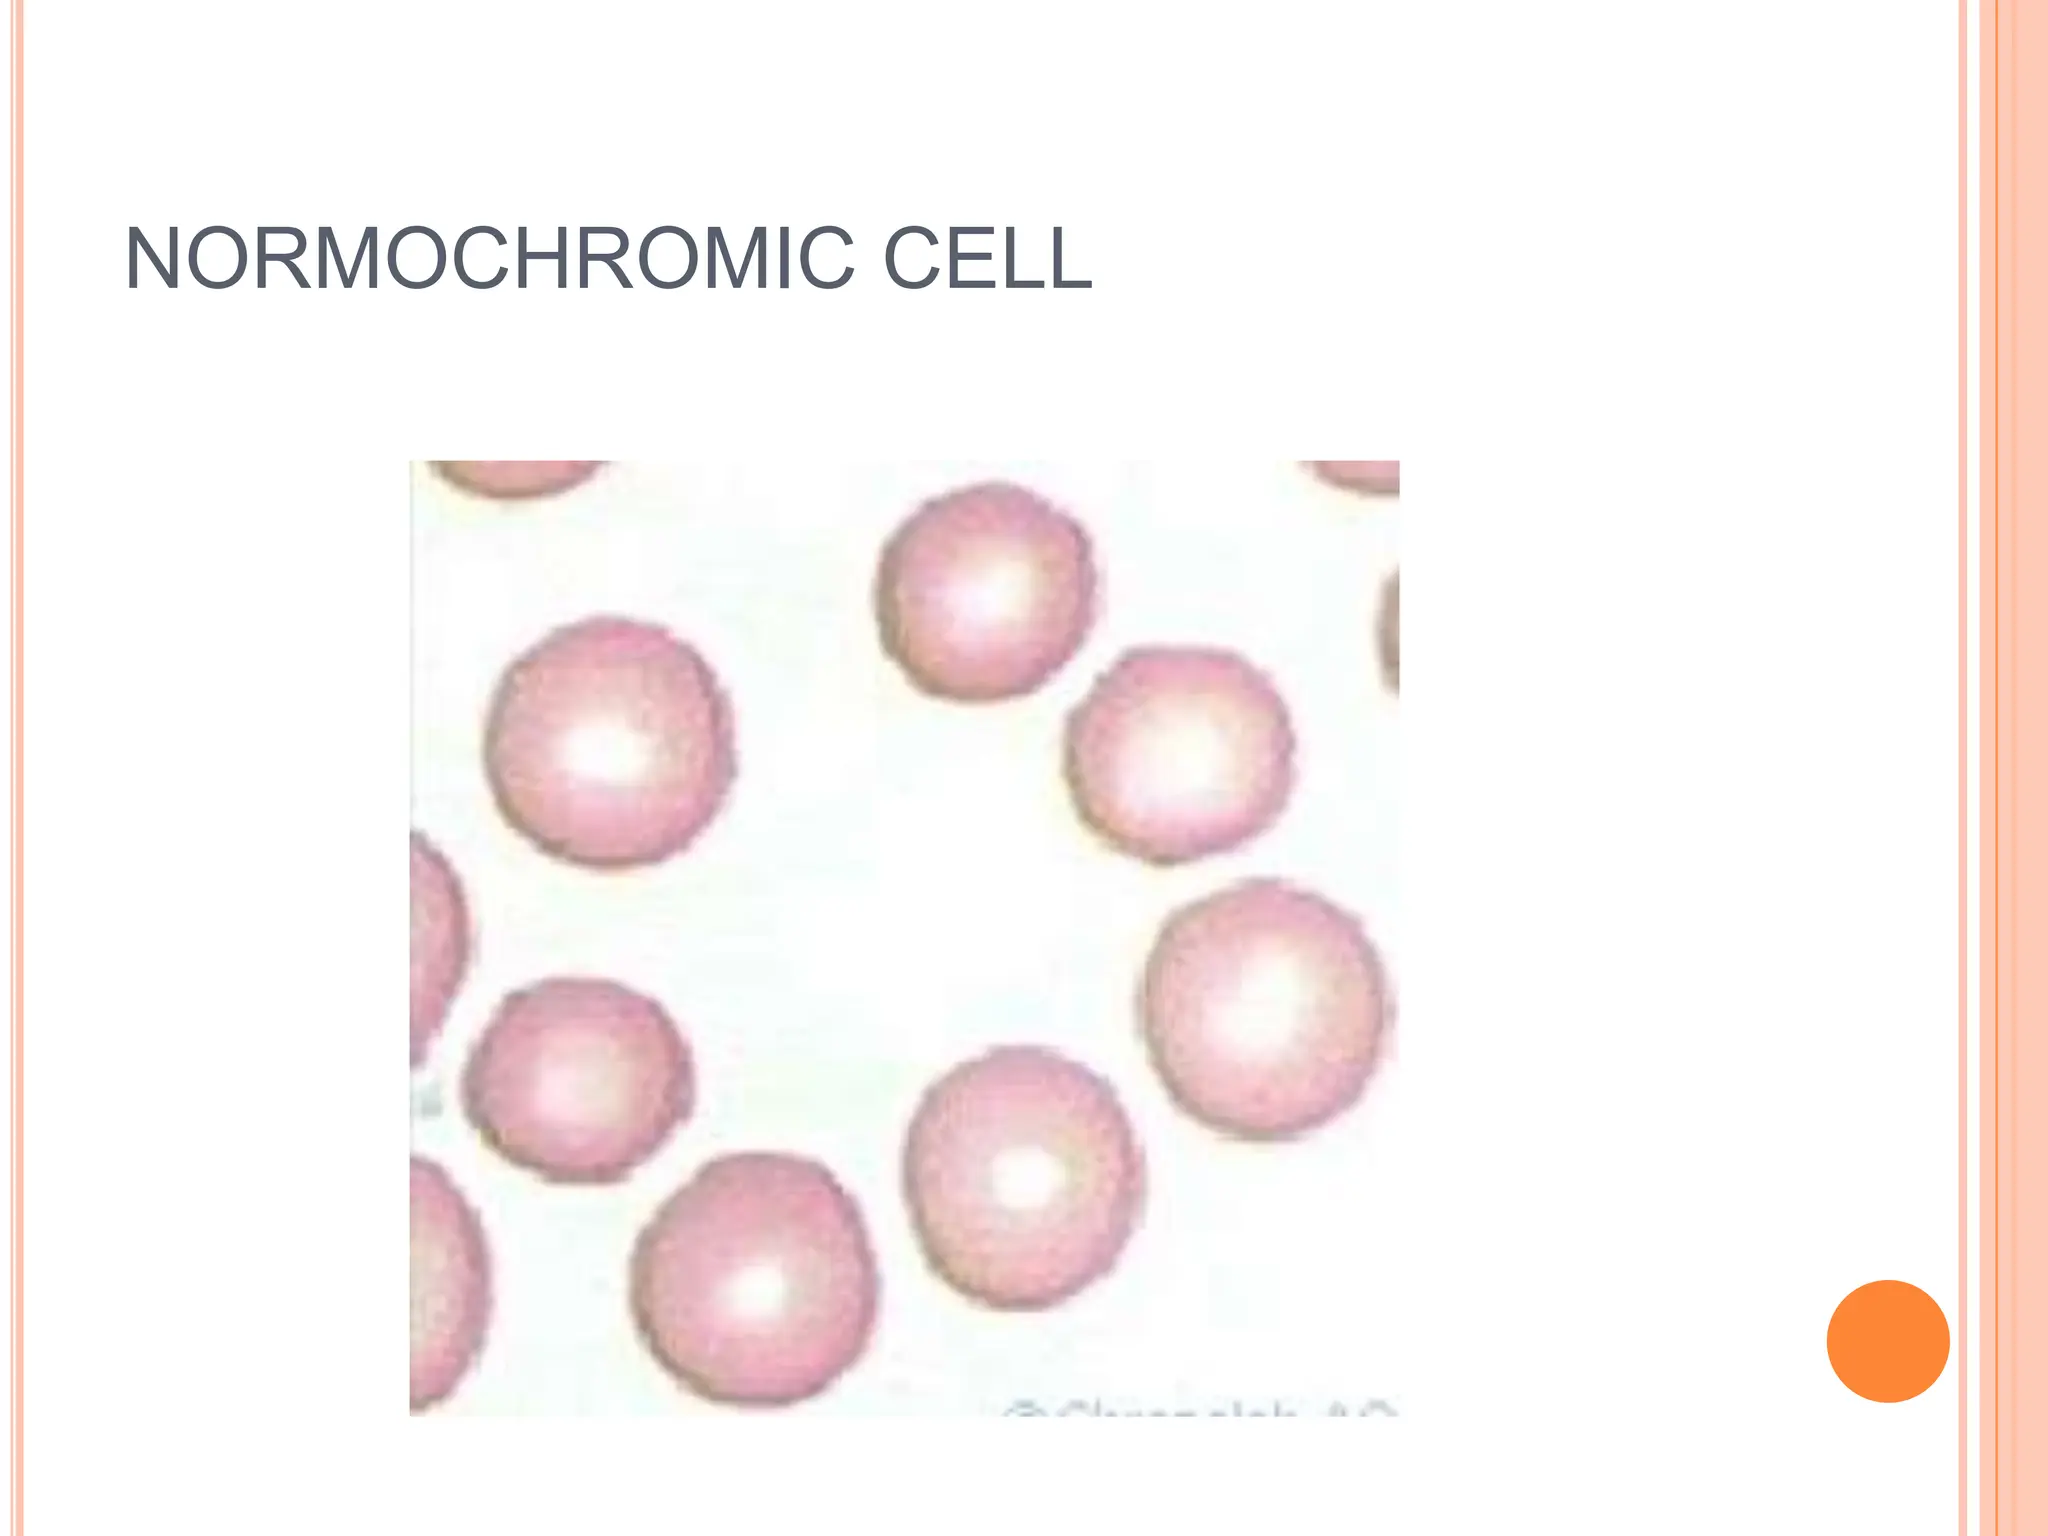
NORMOCHROMIC CELL
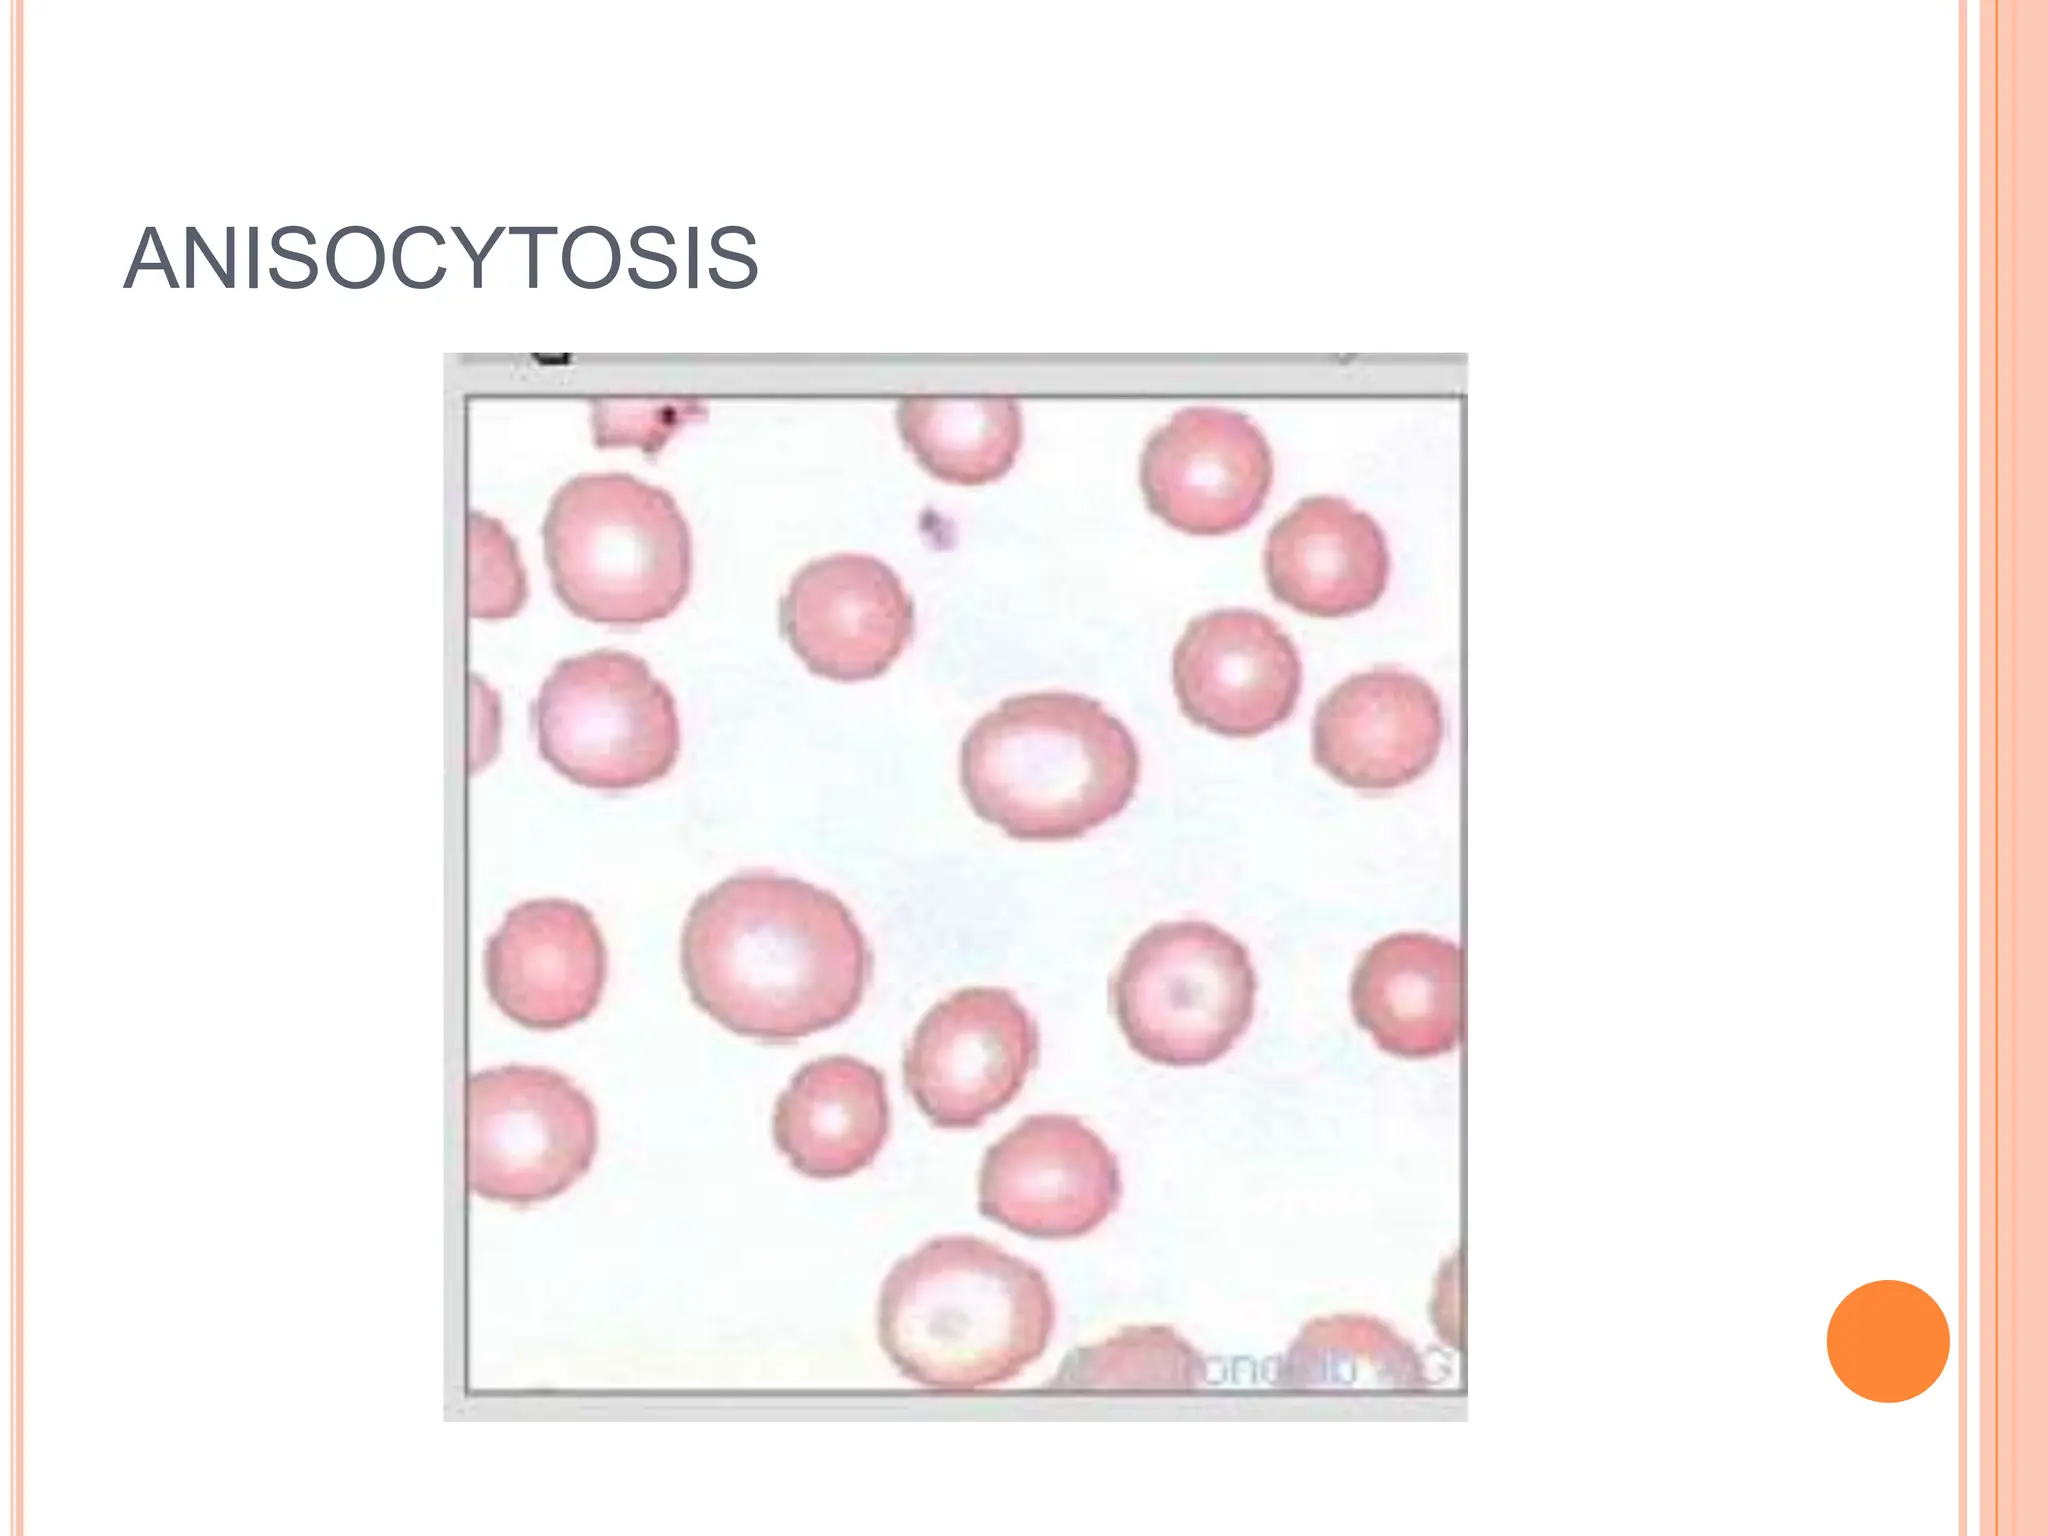
ANISOCYTOSIS
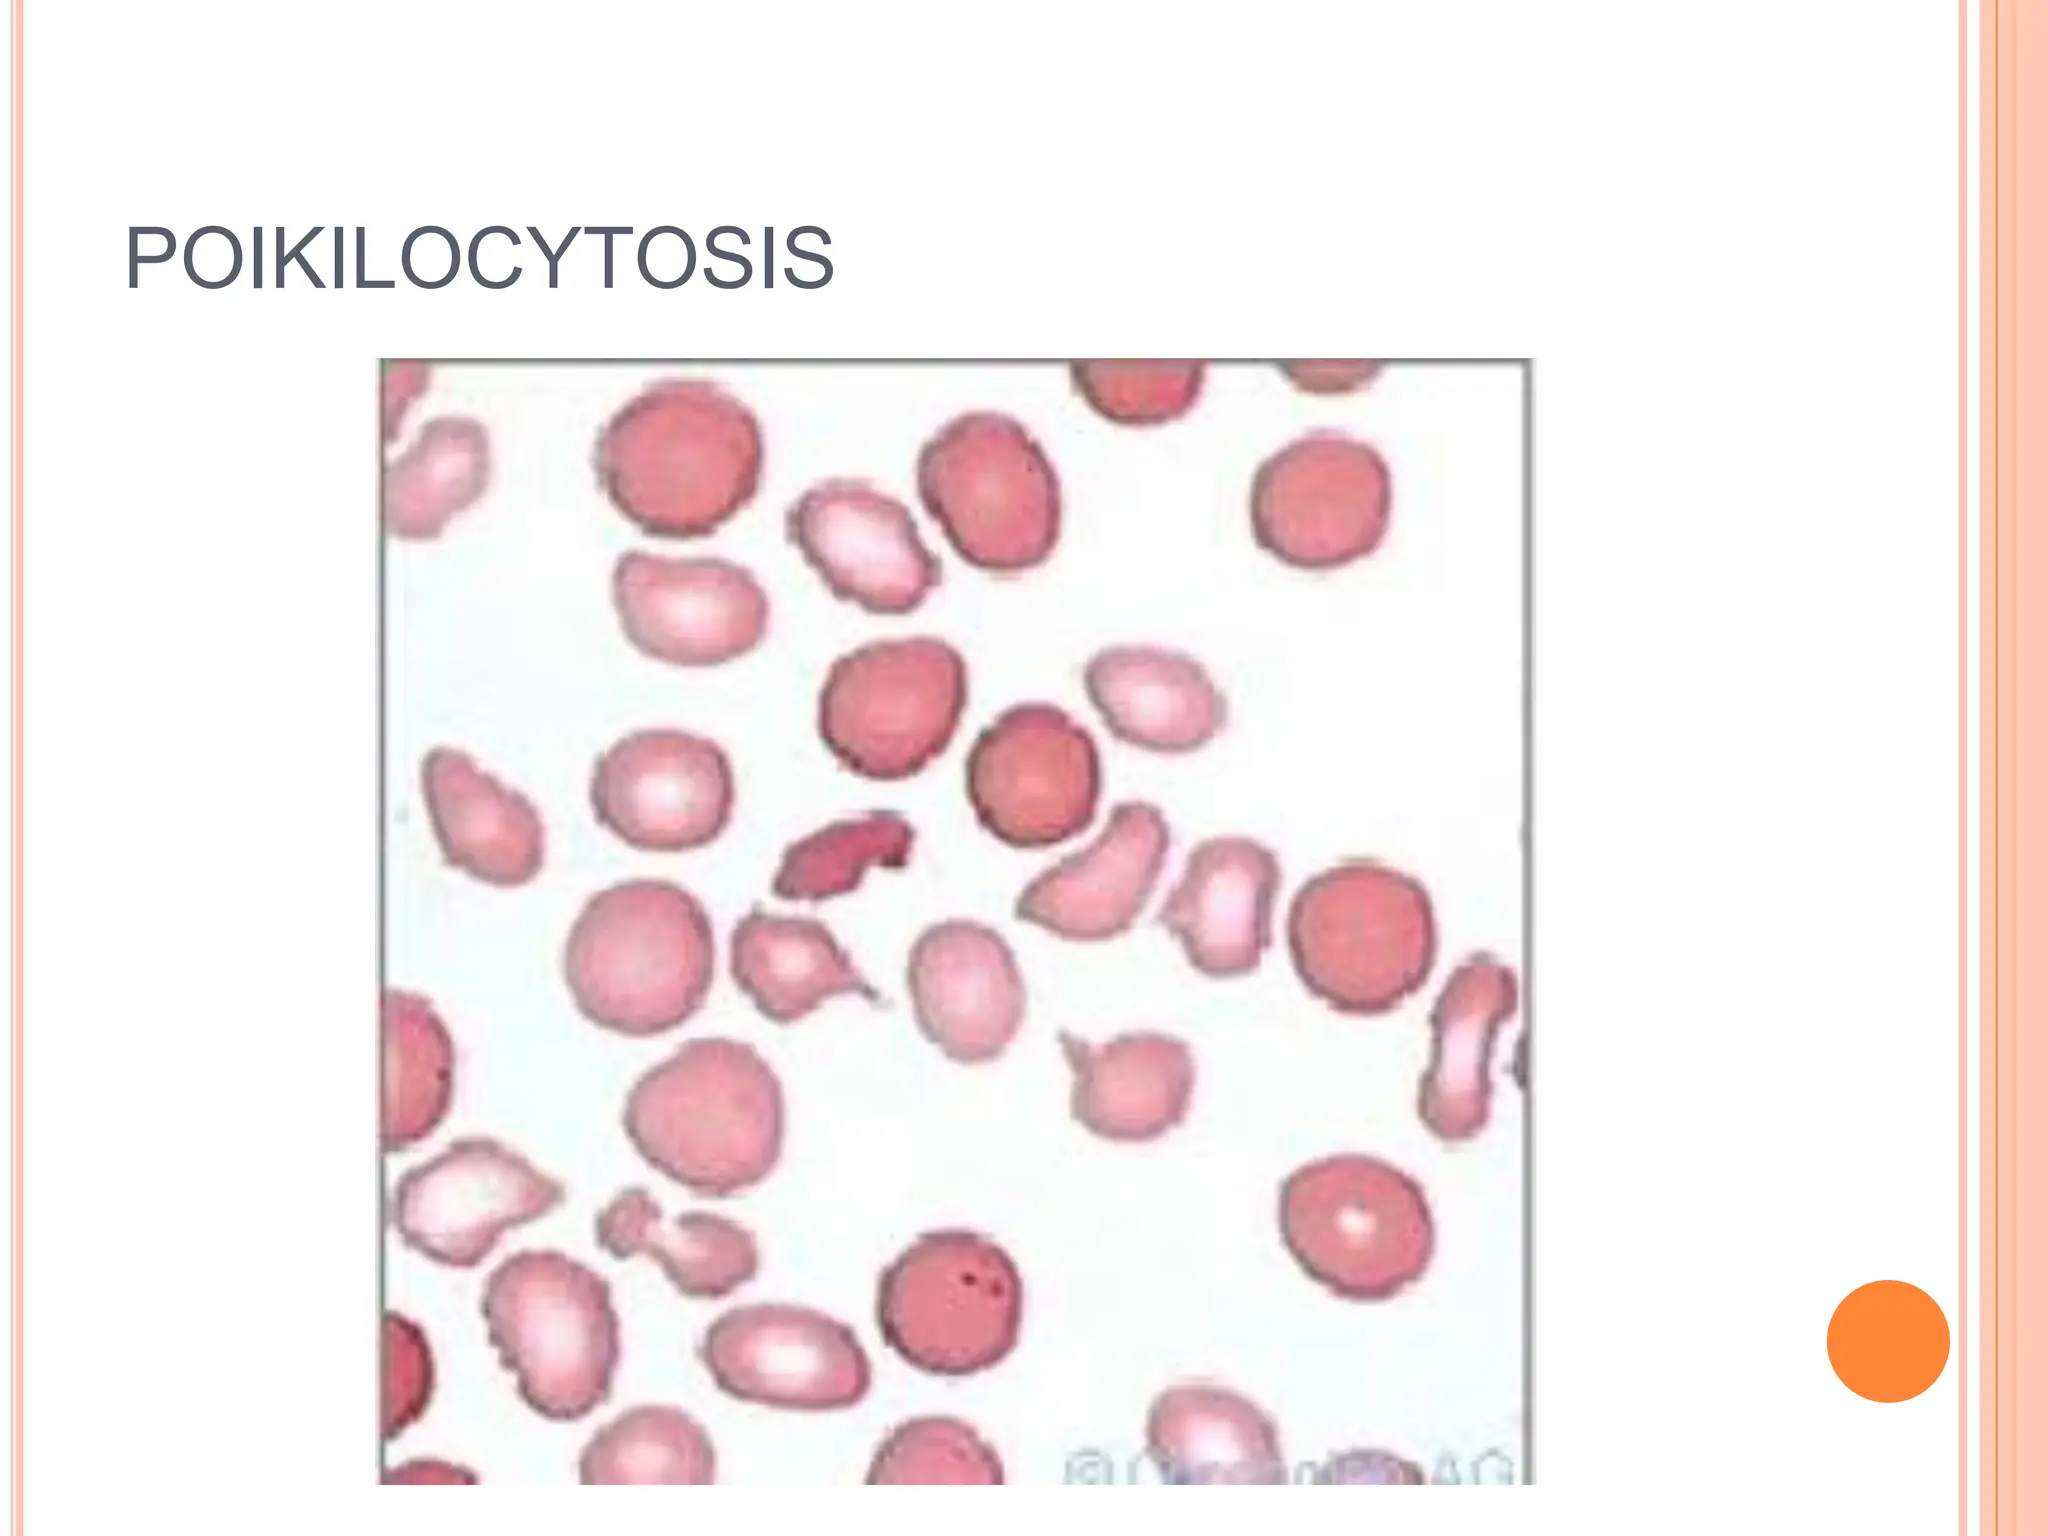
POIKILOCYTOSIS

The document discusses anemia as a condition characterized by inadequate oxygen supply to tissues, often stemming from underlying disorders rather than being a disease itself. It outlines the definitions, causes, symptoms, and diagnostic methods for anemia, emphasizing the importance of patient history, physical exams, and various laboratory tests in identifying the type and severity of anemia. Additionally, it explains the classification of anemias based on morphology and function, highlighting conditions like nutritional deficiencies, blood loss, and bone marrow disorders.